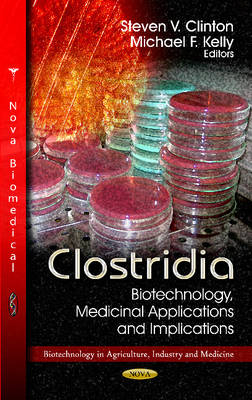
Clostridia -

Clostridia
Biotechnology, Medicinal Applications & Implications
Seiten
2011
Nova Science Publishers Inc (Verlag)
978-1-62100-761-6 (ISBN)
Nova Science Publishers Inc (Verlag)
978-1-62100-761-6 (ISBN)
The genus Clostridium consists of over 295 species of gram-positive, rod-shaped bacteria. These are mostly anaerobes and present ubiquitously in the environment due to their ability to form heat, radiation and chemical resistant spores. In this book, the authors present current research in the study of the biotechnology, medicinal applications and implications of clostridia. Topics discussed include the biodegradation of organic pollutants, reduction of metals and energy generation involving Clostridium sp.; the utilisation of clostridium in industrial, biotechnological and medical endeavours; the clinical aspects of clostridium difficile associated with diarrhoea and the potential use of megasphaera elsdenii as a hydrogen producer.
Preface; Biodegradation of Organic Pollutants, Reduction of Metals & Energy Generation Involving Clostridium sp; Clostridia: Harvesting the Potential Benefits for Humans; Clinical Aspects of Clostridium Difficile Associated Diarrhoea; The Laboratory Diagnosis of Clostridium Difficile Infection; Potential Use of Megasphaera Elsdenii as a Hydrogen Producer; Index.
| Zusatzinfo | Illustrations |
|---|---|
| Verlagsort | New York |
| Sprache | englisch |
| Maße | 155 x 230 mm |
| Gewicht | 308 g |
| Themenwelt | Studium ► 2. Studienabschnitt (Klinik) ► Rechtsmedizin |
| ISBN-10 | 1-62100-761-8 / 1621007618 |
| ISBN-13 | 978-1-62100-761-6 / 9781621007616 |
| Zustand | Neuware |
| Informationen gemäß Produktsicherheitsverordnung (GPSR) | |
| Haben Sie eine Frage zum Produkt? |
Mehr entdecken
aus dem Bereich
aus dem Bereich
Rechtsgrundlagen, praktische Durchführung, Problemlösungen
Buch | Hardcover (2026)
Springer Berlin (Verlag)
CHF 139,95
Ein praktisches Handbuch für Ärzte und Juristen
Buch | Hardcover (2020)
Urban & Fischer in Elsevier (Verlag)
CHF 329,95


